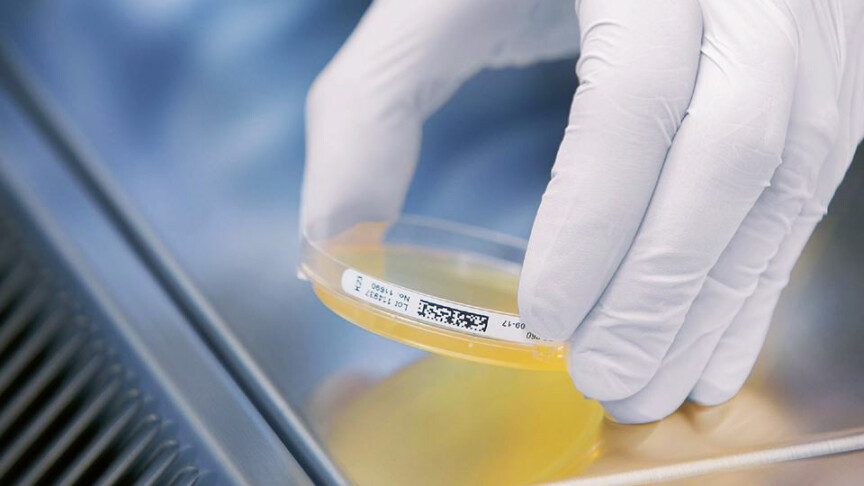
Hygiene Monitoring

31.03.23
Hygiene-Monitoring – die geeignete Messmethode: Die Qual der richtigen Wahl!
Als Hygiene-Monitoring, Neudeutsch für Kontrolle der Hygiene, wird vereinfacht die generelle Überwachung der zur Erhaltung der Gesundheit dienenden Massnahmen betrachtet. Es wird in Pharma-, Biotech-, Kosmetik- und Lebensmittelindustrien sowie auch in Spitalern, Apotheken, Grossküchen und anderen hygienisch anspruchsvollen Bereichen zur Überwachung der Mitarbeiter-, Produkt und Prozesshygiene genutzt.
Zusammenfassung
Als Hygiene-Monitoring, Neudeutsch für Kontrolle der Hygiene, wird vereinfacht die generelle Überwachung der zur Erhaltung der Gesundheit dienenden Massnahmen betrachtet. Dies speziell in Bezug auf diverse mikrobiologische Verunreinigungen, welche zu direkten und indirekten Infektionskrankheiten, chronischen Erkrankungen unterschiedlichster Art, allergischen Reaktionen wie auch Epidemien führen können.
Mikrobiologische Hygienekontrollen von diversen Reinräumen, wie zum Beispiel in der Pharmaproduktion, in Operationssälen und Quarantänezimmern, in der Lebensmittelproduktion, in öffentlichen Räumen und anderen hygienisch sensiblen Bereichen, dienen dazu durch regelmassiges Monitoring die Qualität des eigenen Hygiene-Managements mit handfesten Daten zu belegen und nötigenfalls zu korrigieren.
Letztlich bestätigt das Hygiene-Monitoring die Qualitätssicherung von Produkten und Dienstleistungen aller Art wie auch die Bestrebungen zur Sicherheit von Mitarbeitern, Patienten, Besuchern wie auch Konsumenten, nicht zuletzt aber auch der näheren Umgebung sowie auch der generellen Umwelt.
Hygiene-Monitoring
Basierend auf der EU-Norm EN 17141, «Reinräume und dazugehörige Reinraumbereiche – Biokontaminationskontrolle», – ehemals EN ISO 14698-1:2003 und EN ISO 14698-2:2003 – wird für das mikrobiologische Hygiene Monitoring von Produktionsstätten im regulierten Bereich ein Mix aus Sedimentationsplatten, Probennahme durch Tupfer/Swabs, aktiven Luftkeimmessungen und Oberflächenuntersuchungen mittels Abklatschplatten angewendet.
Die Regularien fordern die regelmässige Durchführung von Monitorings in einer Frequenz, die hoch genug ist, um auftretende Abweichungen frühzeitig zu erkennen und eine statistische Signifikanz der Datenerhebung sicherstellen zu können. Die Frequenz des Monitorings ist abhängig von Faktoren wie der GMP-Klasse des Reinraumes, der Risikobewertung des Produktionsprozesses, dem Reinraum-Design, den Wechselwirkungen mit den Menschen in der direkten Umgebung und von vorhandenen historischen Daten, welche von ausgebildeten Fachexperten evaluiert werden sollten.
Jeder Reinraum-Betreiber steht in der Verantwortung seine Monitoring-Frequenz festzulegen, zu begründen und regelmassig anzupassen. Das Hygiene-Monitoring wird in Pharma-, Biotech-, Kosmetik- und Lebensmittelindustrien sowie auch in Spitalern, Apotheken, Grossküchen und anderen hygienisch anspruchsvollen Bereichen zur Überwachung der Mitarbeiter-, Produkt und Prozesshygiene genutzt.
Die geeignete Messmethode: Die Qual der richtigen Wahl!
Für die Gewinnung der erforderlichen Messdaten stehen verschiedene Messmethoden zur Verfügung. Je nach Art der zu messenden Keime bzw. infektiöser Partikel sollten Entnahmevolumen, Frequenz, Betrachtungszeitraum sowie die geeignete Methode von Spezialisten ausgewählt, durchgeführt und deren Daten sorgfältig ausgewertet und kommuniziert werden. Neben klassischen kulturbasierten mikrobiologischen Messverfahren oder direkten und indirekten Nachweismethoden von direkten und indirekten Hygieneparametern stehen auch schnelle mikrobiologische Verfahren und sowie alternative mikrobiologische Echtzeit-Nachweisverfahren zur Verfügung.
Im spezialisierten Labor oder «vor Ort» beim Kunden
Neben hochspezialisierten Labors zur mikrobiologischen Proben- oder Parameteranalyse und der sehr spezifischen Auswertung der bei den Kontrollen gewonnenen Proben, stehen mit «vor Ort» bzw. «on-site» mikrobiologischen Analysemethoden weitere Technologien für eine bedeutend schnellere und gezieltere Korrektur von bestehenden Hygiene-Massnahmen zur Verfügung.
Während hochspezialisierte Zentrallabors qualitativ und quantitativ sehr gute Resultate mit hoher Genauigkeit, tiefer Nachweisgrenze und hervorragender Spezifität bis auf die DANN-/Genom- und Proteinsequenz Ebene liefern können, sind die einfacheren Methoden der on-site Messungen meist weniger genau und spezifisch. Dafür sind die Resultate bedeutend schneller erhältlich und Korrekturmassnahmen können viel schneller ergriffen werden. Dies ist in allen Bereichen entscheidend, in welchen nicht mehrere Stunden oder Tag auf ein Ergebnis gewartet werden kann.
Eine Kombination und Expertise von spezifischen Laborauswertungen und von schnelleren – oft weniger präzisen – on-site Messmethoden sichert eine hohe Qualität der gesamten Leistungskette – von der effektiven, schnellen und korrekten Datenerhebung und -auswertung, einer fachspezifischen Analyse der Proben, über fachkompetente Schlussfolgerungen bis hin zum Vorschlagen der zu ergreifenden Hygiene-Kontrollmassnahmen.
Generell wird zur mikrobiologischen Kontrolle ein sich selbst optimierendes System auf kontinuierlicher Basis vorgeschlagen, welches identifiziert, durchführt, kontrolliert bzw. überwacht und adaptiert. Dies ist ein klassischer zyklischer Prozess der kontinuierlichen Verbesserung, bei welchem die Grundsätze: Planen – Durchführen – Prüfen – Handeln (PDCA, i.e. Plan, Do, Control und Act), gelten.

Beim Erstellen und Planen einer geeigneten Hygienelösung eines betrieblichen Systems zur mikrobiologischen Kontrolle ist eine angepasste Bioanalytik der zentrale Eckpfeiler. Hierbei gilt es alle potenziellen Quellen und Wege einer mikrobiologischen Kontamination zu identifizieren und entsprechende Lösungen zu planen und vor Ort oder im Labor zu testen. Während der Implementierung und Anwendung wie auch den anderen Phasen der kontinuierlichen Verbesserung können speziell die schnellen on-site Messmethoden helfen ein gewähltes Massnahmenkonzept zu überwachen, zu prüfen, dieses aufrechtzuerhalten oder auch entsprechend zu korrigieren und damit zu verbessern.
Zusammenfassend besteht der Vorteil oder Nutzen einer angepassten Biokontaminationskontrolle aus einer Kombination von verschiedenen Faktoren:
- Wahl der geeigneten vor Ort Analysen und/oder zentralen Laborbestätigungen durch adaptierte und optimierte mikrobiologische Messmethoden; dies als Kombination von «schnell vor Ort» und «genau und spezifisch» im Labor.
- Datenanalyse und Risikobewertung sowie Erstellung eines spezifischen und system-optimierten Überwachungsplanes
- Fachkompetente Empfehlung bei Abweichungen sowie Ergreifen der geeignete Korrekturmassnahmen
- Entscheidend sind aber vor allem kurze Reaktionszeiten für die Durchführung von notwendigen Analysen sowie der Korrektur-, Dekontaminations- und Hygienearbeiten bevor grössere Schäden bei Menschen, Produkten oder der Umwelt entstanden sind.
Spezifische Umsetzung in den verschiedenen Industrien und dem Gesundheitswesen
Es stehen eine Vielzahl verschiedener Anleitung insbesondere für die Pharma-, Biopharma-, Medizinprodukte-Branchen und anderen Life-Science-Branchen wie auch etwa das Gesundheitswesen und Krankenhäusern sowie verwandte Anwendungen zur Verfügung. Allen Bereichen und Branchen sind gemeinsam, dass sie auf hygienische Reinheit oder Sauberkeit hoch-relevante und kontrollierte Bereiche besitzen und/oder benutzen.
In der regulierten pharmazeutischen und biopharmazeutischen Produktionsindustrie bestehen bereits zahlreiche anzuwendende Normen und verordnungsrechtliche Richtlinien. Hierzu zählen der EU-Anhang 1 GMP-Leitfaden zur Herstellung steriler Arzneimittel sowie der FDA-Leitfaden zur aseptischen Herstellung. Die Pharmaverordnungen Europas und der USA enthalten ebenfalls einige Anleitungen zu bestimmten verwandten Themen. Es stehen zahlreiche weitere Dokumente und Fachartikel der Industrieverbände einschließlich der Parenteral Drugs Association (PDA), der International Society of Pharmaceutical Engineering (ISPE) und der Pharmaceutical Healthcare Sciences Society (PHSS) zur Verfügung.
Im Gesundheitswesen- und Krankenhaussektor sind EU-Richtlinien einschließlich der Gewebe- und Blutrichtlinien für Spezialbereiche und ähnliche auf Sauberkeit kontrollierte Bereiche verfügbar. Es stehen nationale Normen und Richtlinien für spezialisierte Operationsräume, Isolierstationen und Stationen für immungeschwächte Patienten als Teil der Infektionskontrolle zur Verfügung. Darüber hinaus nutzen die aseptischen Bereiche zum Anmischen von Arzneimitteln in Krankenhausapotheken, Radiopharmazie-Apotheken und Speziallabors wie Stammzellenlabors üblicherweise Leitfadendokumente aus der Life-Science-Industrie.
Während Verordnungen und Normen zum Risikomanagement von Medizinprodukten wie etwa die EN ISO 14971 verfügbar sind, stehen für die mikrobiologische Kontrolle von weiteren auf generelle Sauberkeit kontrollierten Bereichen meist weniger Anleitungen zur Verfügung.
Auch wenn in der Lebensmittelbranche und verwandten Konsumgüterbranchen Verordnungen und Normen beispielsweise zu Lebensmitteln, Getränken und Kosmetika zur Verfügung stehen, sind nur unzureichende Leitfäden zur mikrobiologischen Kontrolle in auf Sauberkeit kontrollierten Bereichen verfügbar.
Literatur
- DIN EN 17141:2020: Reinräume und zugehörige Reinraumbereiche – Biokontaminationskontrolle
- DIN EN ISO 14698-1:2003: Reinräume und zugehörige Reinraumbereiche – Biokontaminationskontrolle – Teil 1: Allgemeine Grundlagen
- DIN EN ISO 14698-2:2003: Reinräume und zugehörige Reinraumbereiche – Biokontaminationskontrolle – Teil 2: Auswertung und Interpretation von Biokontaminationsdaten
- EN ISO 14644-1:2015: Reinräume und zugehörige Reinraumbereiche – Teil 1: Klassifizierung der Luftreinheit anhand der Partikelkonzentration
- EN ISO 14644-2:2015: Reinräume und zugehörige Reinraumbereiche – Teil 2: Überwachung zum Nachweis der Reinraumleistung bezüglich Luftreinheit anhand der Partikelkonzentration
- EN ISO 14644-3:2005: Reinräume und zugehörige Reinraumbereiche – Teil 3: Prüfverfahren
- EN ISO 14644-4:2001: Reinräume und zugehörige Reinraumbereiche – Teil 4: Planung, Ausführung und Erst-Inbetriebnahme
- EN ISO 14644-5:2004: Reinräume und zugehörige Reinraumbereiche – Teil 5: Betrieb
- EN ISO 14644-7:2004: Reinräume und zugehörige Reinraumbereiche – Teil 7: SD-Module (Reinlufthauben, Handschuhboxen, Isolatoren und Minienvironments)
- Enzler h-tec Einstleistungen – Angewandte Hygienetechnologien
- ISO 14971, Medical devices – Application of risk management to medical devices
- Point H.A.C.C. (HACCP) system and guidelines for its application. 1995 Codex Alimentarius Commission. Alinorm 97/13. Annex to Appendix II. Joint FAO/WHO Food Standards Programme. Food and Agricultural Organization of the United Nations, Rom, 1995.
- European Commission EudraLex „The Rules Governing Medicinal Products in the European Union“, Volume 4.
- EU Guidelines for Good Manufacturing Practice, Medicinal Products for Human and Veterinary Use, Annex 1 – Manufacture of Sterile Medicinal Products, 25. Nov. 2008
- FDA Guidance for Industry – Sterile Drug Products Produced by Aseptic Processing – Current Good Manufacturing Practice. September 2004.
- IS0 18593:2018: Mikrobiologie der Lebensmittelkette – Horizontales Verfahren für Probenahmetechniken von Oberflächen












Sagen Sie uns Ihre Meinung
Schreiben Sie den ersten Kommentar zu diesem Beitrag.
Sie müssen angemeldet sein, um einen Kommentar zu hinterlassen.